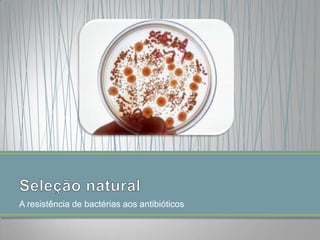
A resistência de bactérias aos antibióticos

O documento discute a seleção natural de Darwin, onde indivíduos com características vantajosas para sobrevivência e reprodução tem maior chance de sobreviver e passar seus genes para a próxima geração. Isso é ilustrado pelo exemplo das mariposas de Manchester, cujas variáveis escuras se tornaram dominantes com a poluição da Revolução Industrial.